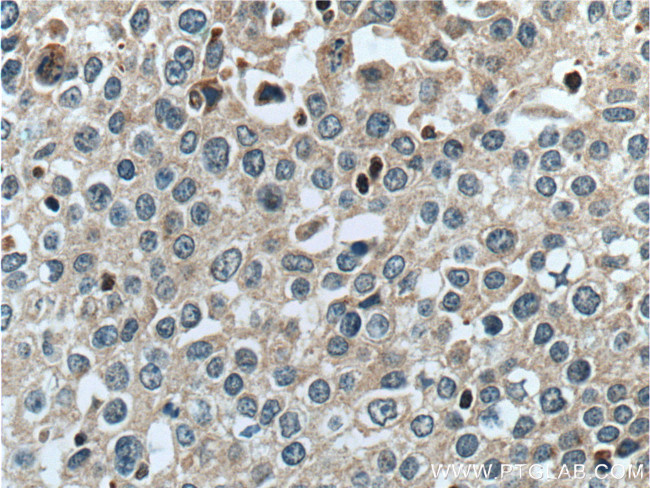
RON/MST1R Antibody in Immunohistochemistry (Paraffin) (IHC (P))

Search
Proteintech
RON/MST1R Polyclonal Antibody
{{$productOrderCtrl.translations['antibody.pdp.commerceCard.promotion.promotions']}}
{{$productOrderCtrl.translations['antibody.pdp.commerceCard.promotion.viewpromo']}}
{{$productOrderCtrl.translations['antibody.pdp.commerceCard.promotion.promocode']}}: {{promo.promoCode}} {{promo.promoTitle}} {{promo.promoDescription}}. {{$productOrderCtrl.translations['antibody.pdp.commerceCard.promotion.learnmore']}}
产品信息
11053-1-AP
种属反应
宿主/亚型
分类
类型
抗原
偶联物
形式
浓度
规格
纯化类型
保存液
内含物
保存条件
运输条件
产品详细信息
Immunogen sequence: ASFSDSEDE SCVPLLRKES IQLRDLDSAL LAEVKDVLIP HERVVTHSDR VIGKGHFGVV YHGEYIDQAQ NRIQCAIKSL SRITEMQQVE AFLREGLLMR GLNHPNVLAL IGIMLPPEGL PHVLLPYMCH GDLLQFIRSP QRNPTVKDLI SFGLQVARGM EYLAEQKFVH RDLAARNCML DESFTVKVAD FGLARDILDR EYYSVQQHRH ARLPVKWMAL ESLQTYRFTT KSDVWSFGVL LWELLTRGAP PYRHIDPFDL THFLAQGRRL PQPEYCPDSL YQVMQQCWEA DPAVRP (1038-1332 aa encoded by BQ936677 NM_002447)
靶标信息
MST1R (RON) is a receptor tyrosine kinase involved in cell proliferation and motility. The protein is a membrane-spanning, disulfide-linked heterodimer, which results from cleavage of a glycosylated precursor into 35-kD (alpha) and 150-kD (beta) subunits. Ligand binding results in tyrosine phosphorylation of the beta chain. In knockout studies, MST1R/RON (-/-) mice failed to survive past the periimplantation period. The MST1R/RON gene has been mapped to 3p21, a region of frequent deletion or mutation in small cell lung and renal carcinoma, and has been implicated in the progression of several epithelial cancers. MST1R/Ron expression has been documented in many normal human tissues. ESTs have been isolated from several tissue libraries, including normal colon, mouth, prostate, and testis and cancerous colon, prostate, stomach, and uteru.
仅用于科研。不用于诊断过程。未经明确授权不得转售。
生物信息学
蛋白别名: c-met-related tyrosine kinase; CD136; CDw136; friend virus susceptibility 2; Macrophage-stimulating protein receptor; MSP receptor; MST1R variant RON30; MST1R variant RON62; p185-Ron; protein tyrosine kinase 8; Protein-tyrosine kinase 8; PTK8 protein tyrosine kinase 8; receptor protein tyrosine kinase, c-met-related; RON variant E2E3; S13 avian erythroblastosis oncogene homolog; S13 erythroblastosis oncogene homolog; Stem cell-derived tyrosine kinase; unnamed protein product
基因别名: CD136; CDw136; Fv-2; Fv2; MST1R; NPCA3; p185-Ron; PTK8; RON; SEA; STK
UniProt ID: (Human) Q04912, (Mouse) Q62190
Entrez Gene ID: (Human) 4486, (Rat) 300999, (Mouse) 19882